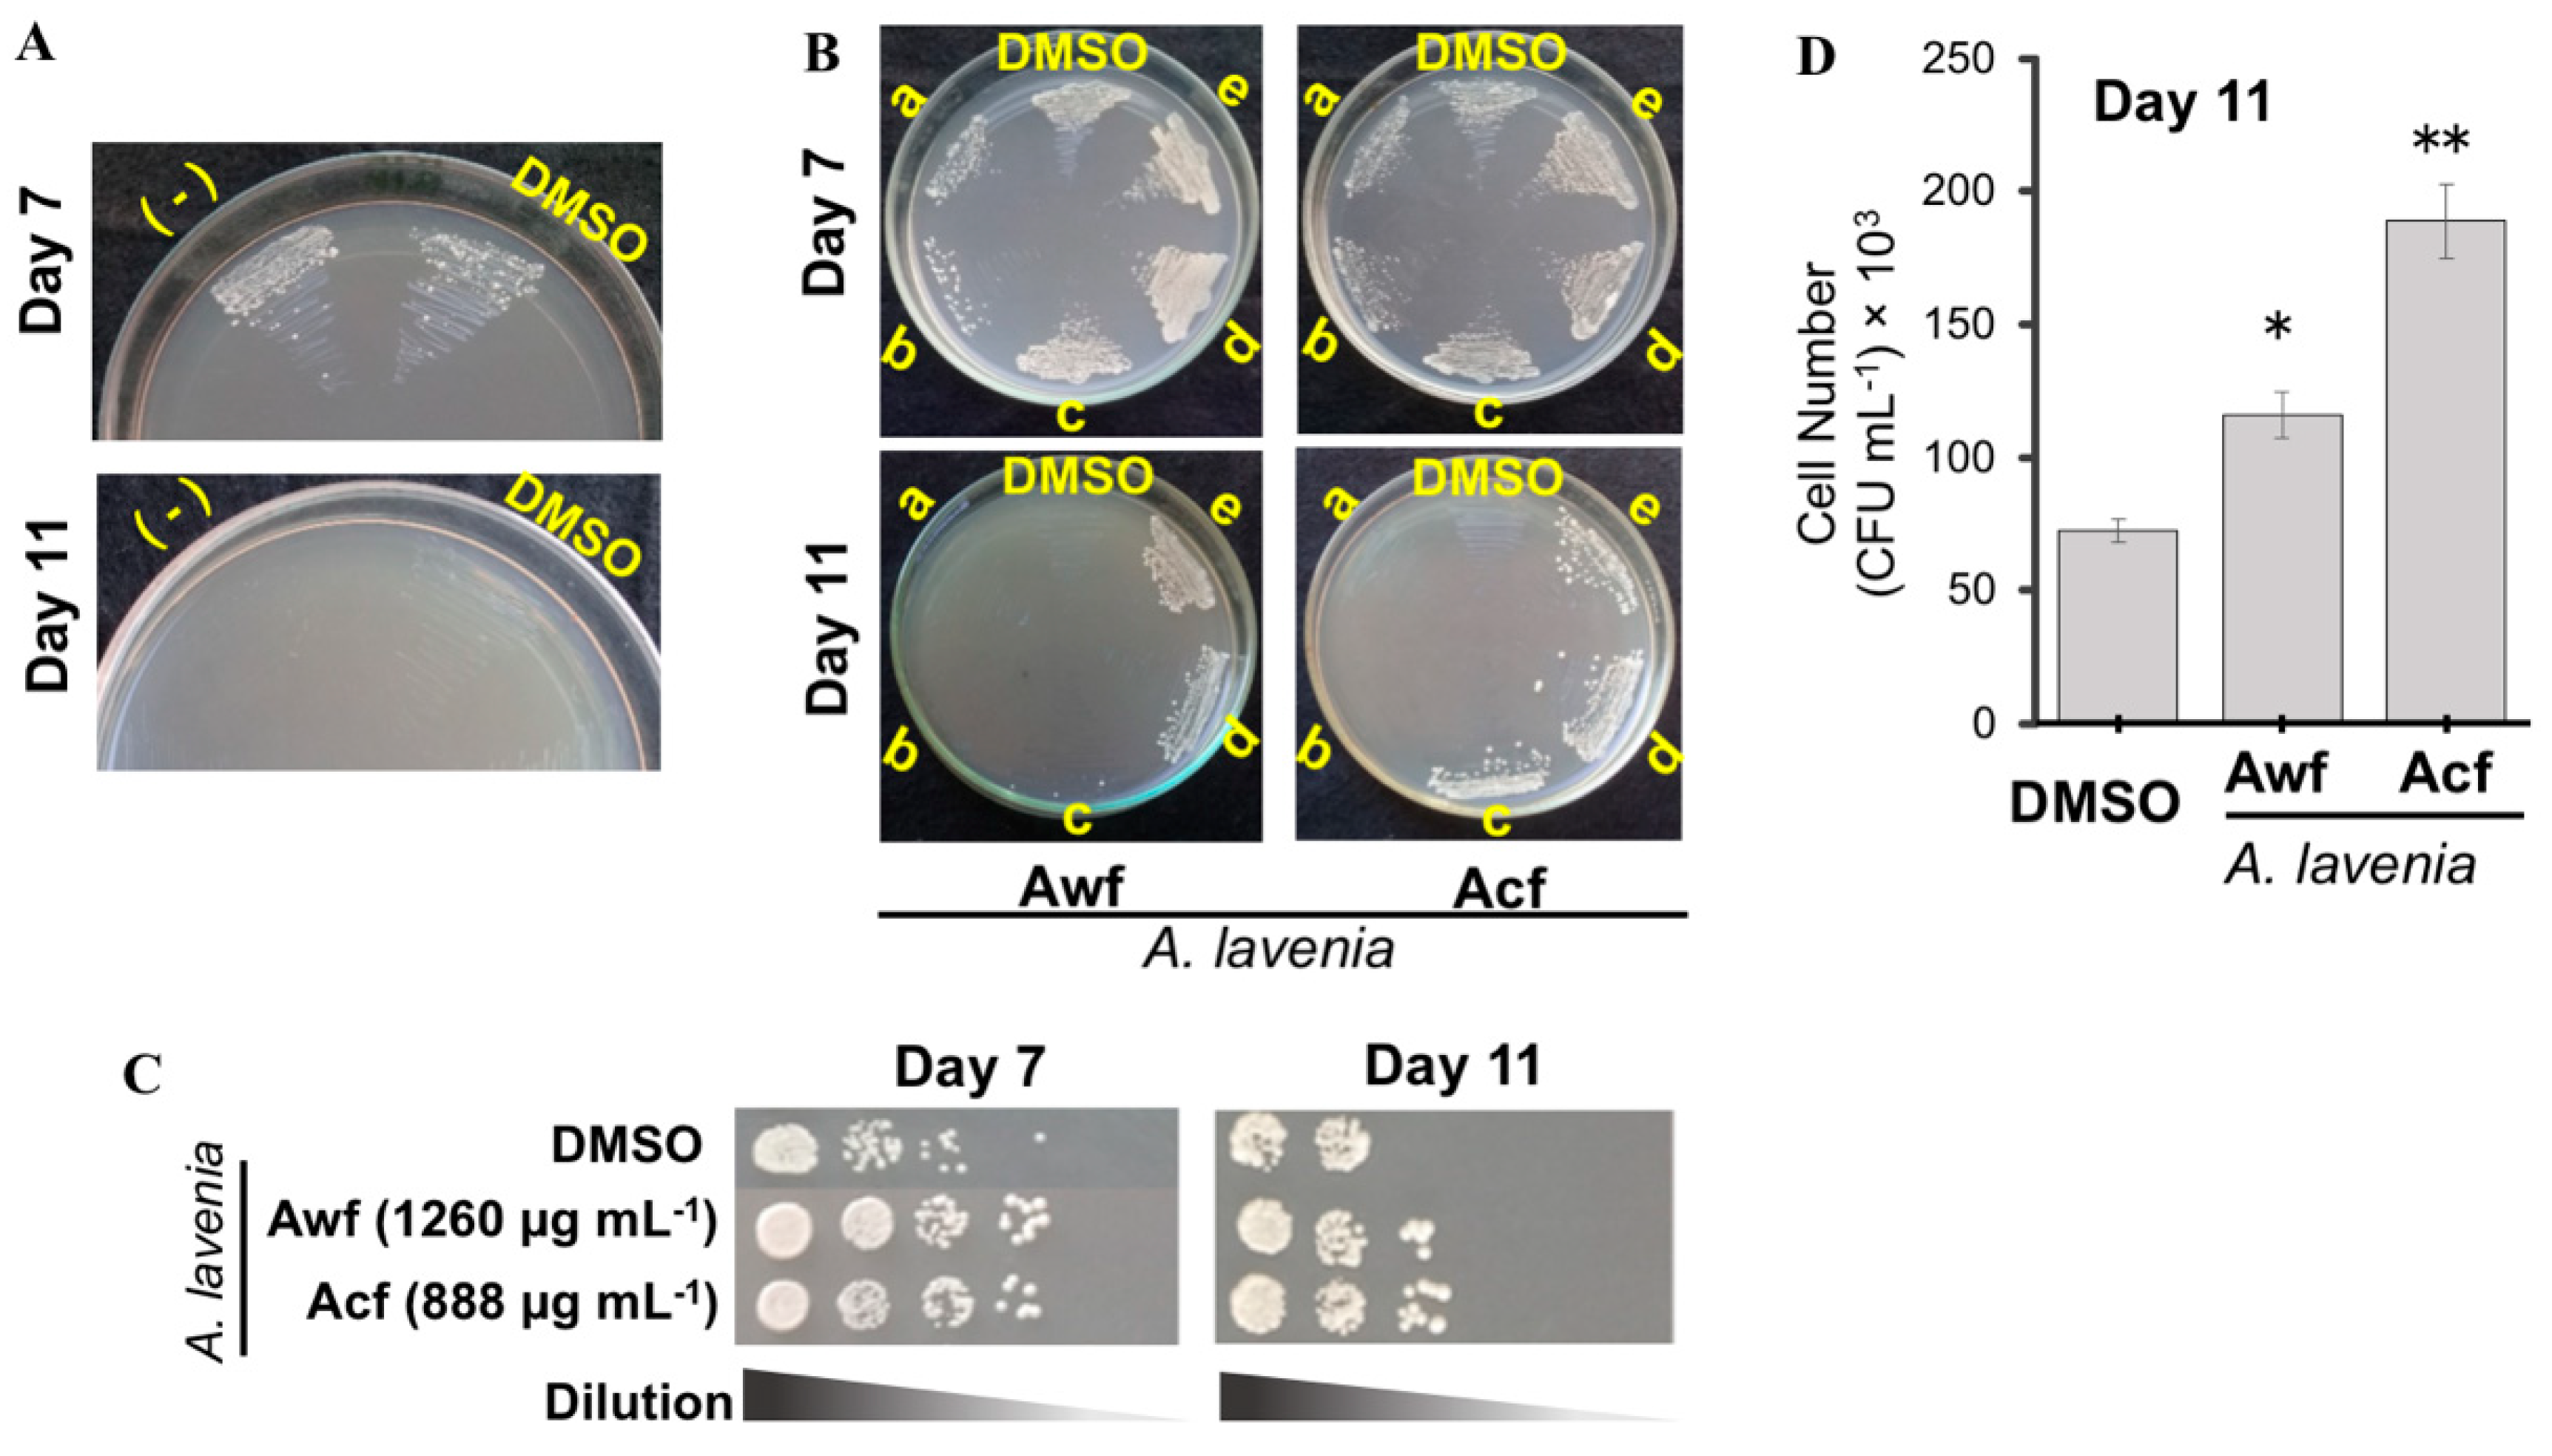
Antioxidants 09 00719 g002 Antioxidants 09 00719 g002

The Antiaging Effect of Active Fractions and Ent-11α-Hydroxy-15-Oxo-Kaur-16-En-19-Oic Acid Isolated from Adenostemma lavenia (L.) O. Kuntze at the Cellular Level
Abstract
1. Introduction
2. Materials and Methods
2.1. 11α-OH-KA
2.2. Cell Culture
2.3. Measurement of Antioxidant and Antiglycation Activities
2.4. Oxidative Stress Tolerance and Survival Assays
2.5. RNA Isolation and Real-Time Quantitative PCR Assay
2.6. Intracellular Yeast Metabolite Extraction and LC-MS Analysis
2.7. Statistical Analyses
3. Results
3.1. Ability of A. lavenia Fractions to Scavenge Free Radicals and Inhibit AGEs Production In Vitro
3.2. Cellular Antioxidant and Antiaging Activities of A. lavenia Extracts
3.3. 11αOH-KA Extends Yeast Life Span
3.4. A. lavenia-Derived Fractions and 11αOH-KA Treatment Increase Mitochondria Activity
3.5. 11αOH-KA Treatment Alters Yeast Intracellular Metabolites Involved in Stress Response Mechanism
3.6. A. lavenia Fractions and 11αOH-KA Upregulate Pap1-Dependent Antioxidant Signaling in Yeast
3.7. 11αOH-KA Upregulates Antioxidant Signaling in Mouse B16F10 Melanoma Cells
4. Discussion
5. Conclusions
Supplementary Materials
Author Contributions
Funding
Conflicts of Interest
References
- Cheng, P.C.; Hufford, C.D.; Doorenbos, N.J. Isolation of 11-hydroxyated kauranic acids from Adenostemma lavenia. J. Nat. Prod. 1979, 42, 183–186. [Google Scholar] [CrossRef]
- Chen, J.J.; Deng, J.S.; Huang, C.C.; Li, P.Y.; Liang, Y.C.; Chou, C.Y.; Huang, G.J. p-Coumaric-acid containing Adenostemma lavenia ameliorates acute lung injury by activating AMPK/Nrf2/HO-1 signaling and improving the anti-oxidant response. Am. J. Chin. Med. 2019, 47, 1–24. [Google Scholar] [CrossRef]
- Budiarti, E.; Batubara, I.; Ilmiawati, A. The potency of Asteraceae plants extracts as antioxidant and antiglycation agent. J. Jamu Indones. 2019, 4, 109–117. [Google Scholar] [CrossRef]
- Hamamoto, A.; Isogai, R.; Maeda, M.; Hayazaki, M.; Horiyama, E.; Takashima, S.; Koketsu, M.; Takemori, H. The high content of Ent-11α-hydroxy-15-oxo-kaur-16-en-19-oic acid in Adenostemma lavenia (L.) O. Kuntze leaf extract: With preliminary in vivo assays. Foods 2020, 9, 73. [Google Scholar] [CrossRef] [PubMed]
- Kuroi, A.; Sugimura, K.; Kumagai, A.; Kohara, A.; Nagaoka, Y.; Kawahara, H.; Yamahara, M.; Kawahara, N.; Takemori, H.; Fuchino, H. The importance of 11alpha-OH, 15-oxo, and 16-en moieties of 11alpha-hydroxy-15-oxo-kaur-16-en-19-oic acid in its inhibitory activity on melanogenesis. Skin Pharmacol. Physiol. 2017, 30, 205–215. [Google Scholar] [CrossRef]
- Zhang, M.; Zhao, C.; Dai, W.; He, J.; Jiao, S.; Li, B. Anti-inflammatory ent-kaurenoic acids and their glycosides from Gochnatia decora. Phytochemistry 2017, 137, 17481. [Google Scholar] [CrossRef] [PubMed]
- Fontana, L.; Partridge, L.; Longo, V.D. Extending healthy life span--from yeast to humans. Science 2010, 328, 321–326. [Google Scholar] [CrossRef] [PubMed]
- Pan, Y. Mitochondria, reactive oxygen species, and chronological aging: A message from yeast. Exp. Gerontol. 2011, 46, 847–852. [Google Scholar] [CrossRef] [PubMed]
- Lin, S.J.; Austriaco, N. Aging and cell death in the other Yeasts, Schizosaccharomyces pombe and Candida albicans. FEMS Yeast Res. 2014, 14, 119–135. [Google Scholar] [CrossRef]
- Ding, A.J.; Zheng, S.Q.; Huang, X.B.; Xing, T.K.; Wu, G.S.; Sun, H.Y.; Qi, S.H.; Luo, H.R. Current perspective in the discovery of anti-aging agents from natural products. Nat. Prod. Bioprospect. 2017, 7, 335–340. [Google Scholar] [CrossRef]
- Prastya, M.E.; Astuti, R.I.; Batubara, I.; Takagi, H.; Wahyudi, A.T. Natural extract and its fractions isolated from the marine bacterium Pseudoalteromonas flavipulchra STILL-33 have antioxidant and anti-aging activities in Schizosaccharomyces pombe. FEMS Yeast Res. 2020, 20, 1–14. [Google Scholar] [CrossRef] [PubMed]
- Stephan, J.; Franke, J.; Ehrenhofer-Murray, A.E. Chemical genetic screen in fission yeast reveals roles for vacuolar acidification, mitochondrial fission, and cellular GMP levels in lifespan extension. Aging Cell 2013, 12, 574–583. [Google Scholar] [CrossRef] [PubMed]
- Roux, A.E.; Chartrand, P.; Ferbeyre, G.; Rokeach, L.A. Fission yeast and other yeasts as emergent models to unravel cellular aging in eukaryotes. J. Gerontol. A Biol. Sci. Med. Sci. 2010, 65, 1–8. [Google Scholar] [CrossRef] [PubMed]
- Toone, W.M.; Kuge, S.; Samuels, M.; Morgan, B.A.; Toda, T.; Jones, N. Regulation of the fission yeast transcription factor Pap1 by oxidative stress: Requirement for the nuclear export factor Crm1 (Exportin) and the stress-activated MAP kinase Sty1/Spc1. Genes Dev. 1998, 12, 1453–1463. [Google Scholar] [CrossRef] [PubMed]
- Bellezza, I.; Tucci, A.; Galli, F.; Grottelli, S.; Mierla, A.L.; Pilolli, F.; Minelli, A. Inhibition of NF-κB nuclear translocation via HO-1 activation underlies alpha-tocopheryl succinate toxicity. J. Nutr. Biochem. 2012, 23, 1583–1591. [Google Scholar] [CrossRef]
- Brigelius-Flohe, R.; Flohe, L. Basic principles and emerging concepts in the redox control of transcription factors. Antioxid. Redox Signal. 2011, 15, 2335–2381. [Google Scholar] [CrossRef] [PubMed]
- Lee, D.F.; Kuo, H.P.; Liu, M.; Chou, C.K.; Xia, W.; Du, Y.; Shen, J.; Chen, C.T.; Huo, L.; Hsu, M.C.; et al. KEAP1 E3 ligase-mediated downregulation of NF-κB signaling by targeting IKKβ. Mol. Cell 2009, 36, 131–140. [Google Scholar] [CrossRef] [PubMed]
- Batubara, I.; Mitsunaga, T.; Ohasi, H. Screening antiacne potency of Indonesian medicinal plants: Antibacterial, lipase inhibition, and antioxidant activities. J. Wood Sci. 2009, 55, 230–235. [Google Scholar] [CrossRef]
- Prastya, M.E.; Astuti, R.I.; Batubara, I.; Wahyudi, A.T. Bacillus sp. SAB E-41- derived extract shows anti-aging properties via ctt1-mediated oxidative stress tolerance response in yeast Schizosaccharomyces pombe. Asian Pac. J. Trop. Biomed. 2018, 8, 533–539. [Google Scholar] [CrossRef]
- Batubara, I.; Zahra, U.; Darusman, K.D.; Maddu, A. Essential oils of zingiberaceae leaves as antioxidants and antiglycation. Indones. J. Essent. Oil 2016, 1, 1–9. [Google Scholar] [CrossRef][Green Version]
- Khoomrung, S.; Martinez, J.L.; Tippmann, S.; Jansa-Ard, S.; Buffing, M.F.; Nicastro, R.; Nielsen, J. Expanded metabolite coverage of Saccharomyces cerevisiae extract through improved chloroform/methanol extraction and tert-butyldimethylsilyl derivatization. Anal. Chem. Res. 2015, 6, 9–16. [Google Scholar] [CrossRef]
- Lin, Y.; Kotakeyama, Y.; Li, J.; Pan, Y.; Matsuura, A.; Ohya, Y.; Yoshida, M.; Xiang, L.; Qi, J. Cucurbitacin B exerts anti-aging effects in yeast by regulating autophagy and oxidative stress. Oxid. Med. Cell. Longev. 2019, 2019, 1–15. [Google Scholar] [CrossRef]
- Kim, S.J.; Kim, H.G.; Kim, B.C.; Park, E.H.; Lim, C.J. Transcriptional regulation of glutathione synthetase in the fission yeast Schizosaccharomyces pombe. Mol. Cells 2004, 18, 242–248. [Google Scholar] [PubMed]
- Simaan, H.; Lev, S.; Horwitz, B.A. Oxidant-sensing pathways in the responses of fungal pathogens to chemical stress signals. Front. Microbiol. 2019, 10, 567. [Google Scholar] [CrossRef] [PubMed]
- D’Autréaux, B.; Toledano, M.B. ROS as signalling molecules: Mechanisms that generate specificity in ROS homeostasis. Nat. Rev. Mol. Cell Biol. 2007, 8, 813–824. [Google Scholar] [CrossRef]
- Zhu, P.Y.; Yin, W.H.; Wang, M.R.; Dang, Y.Y.; Ye, X.Y. Andrographolide suppresses melanin synthesis through Akt/GSK3β/β-catenin signal pathway. J. Dermatol. Sci. 2015, 79, 74–83. [Google Scholar] [CrossRef]
- Mussard, E.; Cesaro, A.; Lespessailles, E.; Legrain, B.; Berteina-Raboin, S.; Toumi, H. Andrographolide, a Natural Antioxidant: An Update. Antioxidants 2019, 8, 571. [Google Scholar] [CrossRef]
- Prasad, A.G.D.; Shyma, T.B.; Raghavendra, M.P. Plants used by the tribes for the treatment of digestive system disorders in Wayanad district, Kerala. J. Appl. Pharm. Sci. 2013, 3, 171–175. [Google Scholar] [CrossRef]
- Bakar, F.; Acikara, O.B.; Ergene, B.; Nebioglu, S.; Citoglu, G.S. Antioxidant activity and phytochemical screening of some Asteraceae plants. Turk. J. Pharm. Sci. 2015, 12, 123–132. [Google Scholar] [CrossRef]
- Mahomoodally, F.; Subratty, A.H.; Gurib-Fakim, A.; Choudhary, M.I. Antioxidant, antiglycation and cytotoxicity evaluation of selected medicinal plants of the Mascarene Islands. BMC Complement Altern. Med. 2012, 12, 165. [Google Scholar] [CrossRef]
- Zimmermann, A.; Hofer, S.; Pendl, T.; Kainz, K.; Madeo, F.; Carmona-Gutierrez, D. Yeast as a tool to identify anti-aging compounds. FEMS Yeast Res. 2018, 18, 1–16. [Google Scholar] [CrossRef] [PubMed]
- Hibi, T.; Ohtsuka, H.; Shimasaki, T.; Inui, S.; Shibuya, M.; Tatsukawa, H.; Kanie, K.; Yamamoto, Y.; Aiba, H. Tschimganine and its derivatives extend the chronological life span of yeast via activation of the Sty1 pathway. Genes Cells 2018, 23, 620–637. [Google Scholar] [CrossRef] [PubMed]
- Schrepfer, E.; Scorrano, L. Mitofusins, from mitochondria to metabolism. Mol. Cell 2016, 61, 683–694. [Google Scholar] [CrossRef] [PubMed]
- Shadel, G.S.; Horvath, T.L. Mitochondrial ROS signaling in organismal homeostasis. Cell 2015, 163, 560–569. [Google Scholar] [CrossRef]
- Prastya, M.E.; Astuti, R.I.; Batubara, I.; Takagi, H.; Wahyudi, A.T. Chemical screening identifies an extract from marine Pseudomonas sp.-PTR-08 as an anti-aging agent that promotes fission yeast longevity by modulating the pap1–ctt1+ pathway and the cell cycle. Mol. Biol. Rep. 2020, 47, 33–43. [Google Scholar] [CrossRef] [PubMed]
- Takagi, H. Proline as a stress protectant in yeast: Physiological functions, metabolic regulations, and biotechnological applications. Appl. Microbiol. Biotechnol. 2008, 81, 211–223. [Google Scholar] [CrossRef]
- Mukai, Y.; Kamei, Y.; Liu, X.; Jiang, S.; Sugimoto, Y. Proline metabolism regulates replicative lifespan in the yeast Saccharomyces cerevisiae. Microb. Cell 2019, 6, 482–490. [Google Scholar] [CrossRef]
- Sasano, Y.; Haitani, Y.; Ohtsu, I.; Shima, J.; Takagi, H. Proline accumulation in baker’s yeast enhances high-sucrose stress tolerance and fermentation ability in sweet dough. Int. J. Food Microbiol. 2012, 152, 40–43. [Google Scholar] [CrossRef]
- Astuti, R.I.; Watanabe, D.; Takagi, H. Nitric oxide signalling and its role in oxidative stress response in Schizosaccharomyces pombe. Nitric Oxide 2016, 52, 29–40. [Google Scholar] [CrossRef]
- Lyu, J.H.; Lee, G.S.; Kim, K.H.; Kim, H.W.; Cho, S.I.; Jeong, S.I.; Kim, H.J.; Ju, Y.S.; Kim, H.K.; Sadikot, R.T.; et al. ent-kaur-16-en-19-oic Acid, isolated from the roots of Aralia continentalis, induces activation of Nrf2. J. Ethnopharmacol. 2011, 137, 1442–1444. [Google Scholar] [CrossRef]
- Zou, H.; Chen, N.; Shi, M.; Xian, M.; Song, Y.; Liu, J. The metabolism and biotechnological application of betaine in microorganism. Appl. Microbiol. Biotechnol. 2016, 100, 3865–3876. [Google Scholar] [CrossRef]
- Thomas, K.C.; Hynes, S.H.; Ingledew, W.M. Effects of particulate materials and osmoprotectants on very-high-gravity ethanolic fermentation by Saccharomyces cerevisiae. Appl. Environ. Microbiol. 1994, 60, 1519–1524. [Google Scholar] [CrossRef] [PubMed]
- Sui, Y.; Liu, J.; Wisniewski, M.; Droby, S.; Norelli, J.; Hershkovitz, V. Pretreatment of the yeast antagonist, Candida oleophila, with glycine betaine increases oxidative stress tolerance in the microenvironment of apple wounds. Int. J. Food. Microbiol. 2012, 157, 45–51. [Google Scholar] [CrossRef] [PubMed]
- Alirezaei, M.; Khoshdel, Z.; Dezfoulian, O.; Rashdipour, M.; Taghadosi, V. Beneficial antioxidant properties of betaine against oxidative stress mediated by levodopa/benserazide in the brain of rats. J. Physiol. Sci. 2015, 65, 243–252. [Google Scholar] [CrossRef] [PubMed]
- Zhang, M.; Zhang, H.; Li, H.; Lai, F.; Li, X.; Tang, Y.; Min, T. Antioxidant mechanism of betaine without free radical scavenging ability. J. Agric. Food Chem. 2016, 64, 7921–7930. [Google Scholar] [CrossRef] [PubMed]
- Horowitz, R.I.; Freeman, P.R. Three novel prevention, diagnostic, and treatment options for COVID-19 urgently necessitating controlled randomized trials. Med. Hypotheses 2020, 143, 109851. [Google Scholar] [CrossRef] [PubMed]
- McCord, J.M.; Hybertson, B.M.; Cota-Gomez, A.; Geraci, K.P.; Gao, B. Nrf2 Activator PB125 ® as a Potential Therapeutic Agent against COVID-19. Antioxidants 2020, 9, 518. [Google Scholar] [CrossRef]
- Cuadrado., A.; Pajares, M.; Benito, C.; Jiménez-Villegas, J.; Escoll, M.; Fernández-Ginés, R.; Yagüe, A.J.G.; Lastra, D.; Manda, G.; Rojo, A.I.; et al. Can Activation of NRF2 Be a Strategy against COVID-19? Trends Pharmacol. Sci. 2020, in press. [Google Scholar] [CrossRef]

| Samples | Fractions | Antioxidant Activities | Antiglycation Activity (% Inhibition of 1000 µg mL−1 Sample) | |
|---|---|---|---|---|
| DPPH IC50 (µg mL−1) | ABTS (mg Trolox/g Sample) | |||
| A. lavenia | H2O (Awf) | 252.02 ± 3.23 * | 3.63 ± 0.41 | 8.87 ± 2.28 * |
| CHCl3 (Acf) | 222.37 ± 1.16 * | 3.24 ± 0.39 | 33.44 ± 4.87 * | |
| Ascorbic acid | 4.06 ± 0.03 | - | - | |
| Aminoguanidine | - | - | 73.00 ± 3.26 | |
| Metabolites | Abundance (%) | |
|---|---|---|
| DMSO | 11αOH-KA | |
| l-Methionine | 0.10 ± 0.01 | 0.07 ± 0.01 * |
| l-Proline | 1.35 ± 0.04 | 0.04 ± 0.01 * |
| Leucine | 0.50 ± 0.03 | 0.53 ± 0.02 |
| l-Phenylalanine | 0.11 ± 0.02 | 0.35 ± 0.06 * |
| l-Serine | 0.17 ± 0.01 | 0.27 ± 0.01 * |
| l-Tyrosine | 0.13 ± 0.01 | 0.20 ± 0.01 * |
| Betaine | 0.66 ± 0.20 | 4.96 ± 0.32 * |
| l-Arginine | 0.18 ± 0.01 | 0.08 ± 0.01 * |
| l-Glutamic acid | 0.21 ± 0.02 | 0.32 ± 0.02 * |
| 1-Methylguanosine | 0.55 ± 0.01 | 0.32 ± 0.03 * |
| l-Lactic acid | 0.22 ± 0.01 | 0.08 ± 0.01 * |
| d-Glucose | 0.08 ± 0.01 | 0.65 ± 0.03 * |
| Choline | 0.07 ± 0.01 | 0.13 ± 0.01 * |
| Biotin | 4.07 ± 0.22 | 4.33 ± 0.62 |
| Nicotinamide | 0.17 ± 0.01 | 0.09 ± 0.01 * |
© 2020 by the authors. Licensee MDPI, Basel, Switzerland. This article is an open access article distributed under the terms and conditions of the Creative Commons Attribution (CC BY) license (http://creativecommons.org/licenses/by/4.0/).
Share and Cite
Batubara, I.; Astuti, R.I.; Prastya, M.E.; Ilmiawati, A.; Maeda, M.; Suzuki, M.; Hamamoto, A.; Takemori, H. The Antiaging Effect of Active Fractions and Ent-11α-Hydroxy-15-Oxo-Kaur-16-En-19-Oic Acid Isolated from Adenostemma lavenia (L.) O. Kuntze at the Cellular Level. Antioxidants 2020, 9, 719. https://doi.org/10.3390/antiox9080719
Batubara I, Astuti RI, Prastya ME, Ilmiawati A, Maeda M, Suzuki M, Hamamoto A, Takemori H. The Antiaging Effect of Active Fractions and Ent-11α-Hydroxy-15-Oxo-Kaur-16-En-19-Oic Acid Isolated from Adenostemma lavenia (L.) O. Kuntze at the Cellular Level. Antioxidants. 2020; 9(8):719. https://doi.org/10.3390/antiox9080719
Chicago/Turabian StyleBatubara, Irmanida, Rika Indri Astuti, Muhammad Eka Prastya, Auliya Ilmiawati, Miwa Maeda, Mayu Suzuki, Akie Hamamoto, and Hiroshi Takemori. 2020. "The Antiaging Effect of Active Fractions and Ent-11α-Hydroxy-15-Oxo-Kaur-16-En-19-Oic Acid Isolated from Adenostemma lavenia (L.) O. Kuntze at the Cellular Level" Antioxidants 9, no. 8: 719. https://doi.org/10.3390/antiox9080719
APA StyleBatubara, I., Astuti, R. I., Prastya, M. E., Ilmiawati, A., Maeda, M., Suzuki, M., Hamamoto, A., & Takemori, H. (2020). The Antiaging Effect of Active Fractions and Ent-11α-Hydroxy-15-Oxo-Kaur-16-En-19-Oic Acid Isolated from Adenostemma lavenia (L.) O. Kuntze at the Cellular Level. Antioxidants, 9(8), 719. https://doi.org/10.3390/antiox9080719

